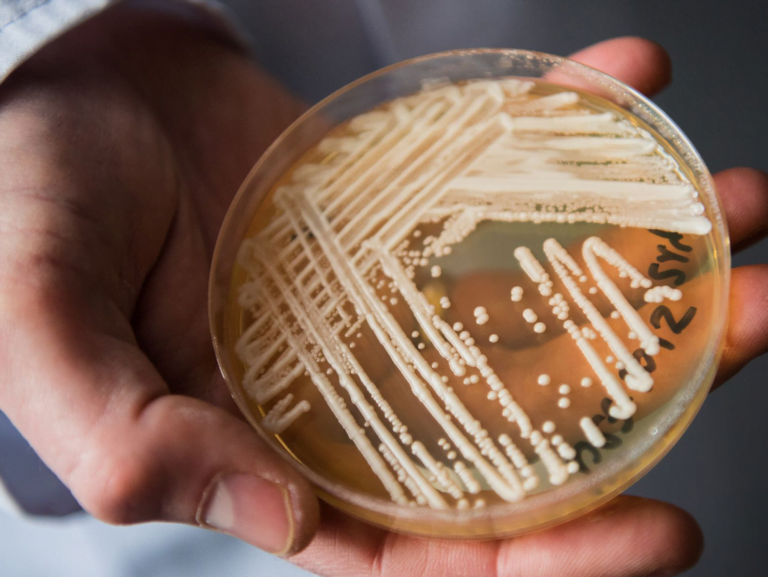

Sabesp: Proposta de privatização busca benefícios à população e metas de saneamento

O governo do Estado de São Paulo divulgou nesta quarta-feira, 7, um cronograma para o estudo de viabilidade da privatização da Sabesp. Essa proposta foi uma promessa de campanha do governador Tarcísio de Freitas (Republicanos) durante as eleições ao Palácio…